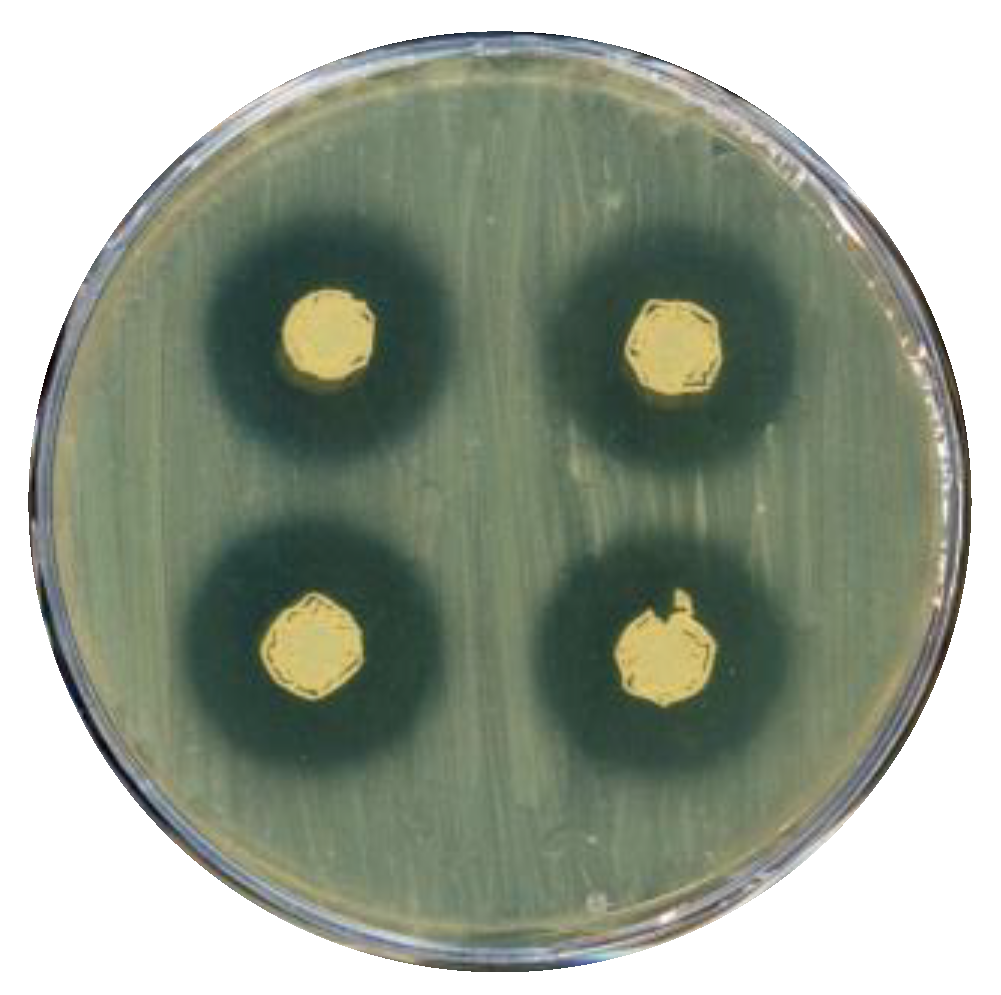
Microorganisms 11 00902 g003

Saccharopolyspora sp. NFXS83 in Marine Biotechnological Applications: From Microalgae Growth Promotion to the Production of Secondary Metabolites
Abstract
1. Introduction
2. Materials and Methods
2.1. Isolation and Identification of Strain NFXS83
2.2. Characterization and Biotechnological Potential of Saccharopolyspora sp. NFXS83
2.2.1. Production of Extracellular Lytic Enzymes
2.2.2. Biosynthesis of Indole-3-Acetic Acid (IAA) and Other Indolic Compounds
2.2.3. Screening for Antimicrobial Activity
2.2.4. Microalgae (Phaeodactylum tricornutum CCAP 1055/1) Growth Promotion Assay
2.3. Saccharopolyspora sp. NFXS83 Genome Sequencing and Analysis
3. Results and Discussion
3.1. 16S rRNA-Based Identification and Phylogenomic Analysis of Strain NFXS83
3.2. Characterization of Saccharopolyspora sp. NFXS83
3.2.1. Production of Extracellular Lytic Enzymes in Marine Media
3.2.2. Synthesis of Indole-3-Acetic Acid (IAA) and other Indolic Compounds
3.2.3. Antimicrobial Activity of Saccharopolyspora sp. NFXS83
3.3. Saccharopolyspora sp. NFXS83 Promoted the Growth of Phaeodactylum tricornutum CCAP 1055/1
3.4. General Properties of Saccharopolyspora sp. NFXS83 Genome
3.5. Genomic Insights into Saccharopolyspora sp. NFXS83 Lytic Enzymes
3.5.1. Glycosyl Hydrolases and Pectate Lyase Family Enzymes
3.5.2. Lipases, Esterases and Proteases
3.6. Saccharopolyspora sp. NFXS83 Presents a Wide Range of Gene Clusters Involved in Secondary Metabolite Production
3.6.1. BGC 1
3.6.2. BGCs 2, 3, 4, 7, 8, 10, 11
3.7. Genomic Insights into the Microalgae-Growth Promoting Properties of Saccharopolyspora sp. NFXS83
4. Conclusions
Supplementary Materials
Author Contributions
Funding
Data Availability Statement
Acknowledgments
Conflicts of Interest
References
- Azam, F.; Fenchel, T.; Field, J.; Gray, J.; Meyer-Reil, L.; Thingstad, F. The ecological role of water-column microbes. Mar. Ecol. Prog. Ser. 1983, 10, 257–263. [Google Scholar] [CrossRef]
- Subramani, R.; Sipkema, D. Marine Rare Actinomycetes: A Promising Source of Structurally Diverse and Unique Novel Natural Products. Mar. Drugs 2019, 17, 249. [Google Scholar] [CrossRef] [PubMed]
- Velmurugan, P.; Venil, C.K.; Veera Ravi, A.; Dufossé, L. Marine Bacteria Is the Cell Factory to Produce Bioactive Pigments: A Prospective Pigment Source in the Ocean. Front. Sustain. Food Syst. 2020, 4, 234. [Google Scholar] [CrossRef]
- González, V.; Vargas-Straube, M.J.; Beys-Da-Silva, W.O.; Santi, L.; Valencia, P.; Beltrametti, F.; Cámara, B. Enzyme Bioprospection of Marine-Derived Actinobacteria from the Chilean Coast and New Insight in the Mechanism of Keratin Degradation in Streptomyces sp. G11C. Mar. Drugs 2020, 18, 537. [Google Scholar] [CrossRef] [PubMed]
- Jagannathan, S.V.; Manemann, E.M.; Rowe, S.E.; Callender, M.C.; Soto, W. Marine Actinomycetes, New Sources of Biotechnological Products. Mar. Drugs 2021, 19, 365. [Google Scholar] [CrossRef] [PubMed]
- Agogué, H.; Casamayor, E.O.; Bourrain, M.; Obernosterer, I.; Joux, F.; Herndl, G.J.; Lebaron, P. A survey on bacteria inhabiting the sea surface microlayer of coastal ecosystems. FEMS Microbiol. Ecol. 2005, 54, 269–280. [Google Scholar] [CrossRef] [PubMed]
- Jose, P.A.; Jha, B. Intertidal marine sediment harbours Actinobacteria with promising bioactive and biosynthetic potential. Sci. Rep. 2017, 7, 1–15. [Google Scholar] [CrossRef] [PubMed]
- Claverías, F.P.; Undabarrena, A.; González, M.; Seeger, M.; Cámara, B. Culturable diversity and antimicrobial activity of Actinobacteria from marine sediments in Valparaíso bay, Chile. Front. Microbiol. 2015, 6, 737. [Google Scholar] [CrossRef] [PubMed]
- Axenov-Gribanov, D.V.; Kostka, D.V.; Vasilieva, U.A.; Shatilina, Z.M.; Krasnova, M.E.; Pereliaeva, E.V.; Zolotovskaya, E.D.; Morgunova, M.M.; Rusanovskaya, O.O.; Timofeyev, M.A. Cultivable Actinobacteria First Found in Baikal Endemic Algae Is a New Source of Natural Products with Antibiotic Activity. Int. J. Microbiol. 2020, 2020. [Google Scholar] [CrossRef]
- Majithiya, V.R.; Gohel, S.D.; Majithiya, V.R.; Gohel, S.D. Actinobacteria Associated with Marine Invertebrates: Diversity and Biological Significance. Actinobacteria—Divers. Appl. Med. Asp. 2022. [Google Scholar] [CrossRef]
- Zhang, H.; Zhang, S.; Peng, Y.; Li, Y.; Chen, Z.; Xu, H.; Yu, Z.; Zheng, W.; Zheng, T. Effects of marine actinomycete on the removal of a toxicity alga Phaeocystis globose in eutrophication waters. Front. Microbiol. 2015, 6, 474. [Google Scholar] [CrossRef] [PubMed]
- Siro, G.; Pipite, A.; Christi, K.; Srinivasan, S.; Subramani, R. Marine Actinomycetes Associated with Stony Corals: A Potential Hotspot for Specialized Metabolites. Microorganisms 2022, 10, 1349. [Google Scholar] [CrossRef] [PubMed]
- De Carvalho, C.C.C.R.; Fernandes, P. Production of metabolites as bacterial responses to the marine environment. Mar. Drugs 2010, 8, 705–727. [Google Scholar] [CrossRef] [PubMed]
- Sayed, A.M.; Abdel-Wahab, N.M.; Hassan, H.M.; Abdelmohsen, U.R. Saccharopolyspora: An underexplored source for bioactive natural products. J. Appl. Microbiol. 2020, 128, 314–329. [Google Scholar] [CrossRef] [PubMed]
- Hung, P.P.; Marks, C.L.; Tardrew, P.L. Isolation and characterization of a new antibiotic, abbott 29119, from streptomyces erythreus. Appl. Microbiol. 1965, 13, 216–217. [Google Scholar] [CrossRef] [PubMed]
- Vanden Boom, T.J. Recent developments in the molecular genetics of the erythromycin-producing organism Saccharopolyspora erythraea. Adv. Appl. Microbiol. 2000, 47, 79–111. [Google Scholar] [CrossRef] [PubMed]
- Galkiewicz, J.P.; Kellogg, C.A. Cross-Kingdom Amplification Using Bacteria-Specific Primers: Complications for Studies of Coral Microbial Ecology. Appl. Environ. Microbiol. 2008, 74, 7828. [Google Scholar] [CrossRef]
- Edgar, R.C. MUSCLE: Multiple sequence alignment with high accuracy and high throughput. Nucleic Acids Res. 2004, 32, 1792–1797. [Google Scholar] [CrossRef]
- Stecher, G.; Tamura, K.; Kumar, S. Molecular Evolutionary Genetics Analysis (MEGA) for macOS. Mol. Biol. Evol. 2020. [Google Scholar] [CrossRef]
- Schneider, C.A.; Rasband, W.S.; Eliceiri, K.W. NIH Image to ImageJ: 25 years of image analysis. Nat. Methods 2012, 9, 671–675. [Google Scholar] [CrossRef]
- Glickmann, E.; Dessaux, Y. A critical examination of the specificity of the salkowski reagent for indolic compounds produced by phytopathogenic bacteria. Appl. Environ. Microbiol. 1995, 61, 793–796. [Google Scholar] [CrossRef] [PubMed]
- Li, F.L.; Wang, L.J.; Fan, Y.; Parsons, R.L.; Hu, G.R.; Zhang, P.Y. A rapid method for the determination of fucoxanthin in diatom. Mar. Drugs 2018, 16, 33. [Google Scholar] [CrossRef]
- Bolger, A.M.; Lohse, M.; Usadel, B. Trimmomatic: A flexible trimmer for Illumina sequence data. Bioinformatics 2014, 30, 2114–2120. [Google Scholar] [CrossRef] [PubMed]
- Bankevich, A.; Nurk, S.; Antipov, D.; Gurevich, A.; Dvorkin, M.; Kulikov, A.S.; Lesin, V.M.; Nikolenko, S.I.; Pham, S.; Prjibelski, A.D.; et al. SPAdes: A new genome assembly algorithm and its applications to single-cell sequencing. J. Comput. Biol. 2012, 19, 455–477. [Google Scholar] [CrossRef]
- Angiuoli, S.V.; Gussman, A.; Klimke, W.; Cochrane, G.; Field, D.; Garrity, G.M.; Kodira, C.D.; Kyrpides, N.; Madupu, R.; Markowitz, V.; et al. Toward an Online Repository of Standard Operating Procedures (SOPs) for (Meta)genomic Annotation. Omi. A J. Integr. Biol. 2008, 12, 137–141. [Google Scholar] [CrossRef]
- Kanehisa, M.; Sato, Y.; Morishima, K. BlastKOALA and GhostKOALA: KEGG Tools for Functional Characterization of Genome and Metagenome Sequences. J. Mol. Biol. 2016, 428, 726–731. [Google Scholar] [CrossRef] [PubMed]
- Altschul, S.F.; Gish, W.; Miller, W.; Myers, E.W.; Lipman, D.J. Basic local alignment search tool. J. Mol. Biol. 1990, 215. [Google Scholar] [CrossRef]
- UniProt: The universal protein knowledgebase. Nucleic Acids Res. 2017, 45, D158–D169. [CrossRef]
- Kearse, M.; Moir, R.; Wilson, A.; Stones-Havas, S.; Cheung, M.; Sturrock, S.; Buxton, S.; Cooper, A.; Markowitz, S.; Duran, C.; et al. Geneious Basic: An integrated and extendable desktop software platform for the organization and analysis of sequence data. Bioinformatics 2012, 28, 1647–1649. [Google Scholar] [CrossRef]
- Zhang, H.; Yohe, T.; Huang, L.; Entwistle, S.; Wu, P.; Yang, Z.; Busk, P.K.; Xu, Y.; Yin, Y. dbCAN2: A meta server for automated carbohydrate-active enzyme annotation. Nucleic Acids Res. 2018, 46, W95–W101. [Google Scholar] [CrossRef]
- Mulder, N.; Apweiler, R. InterPro and InterProScan. Comp. Genomics 2007, 2, 59–70. [Google Scholar] [CrossRef]
- Rawlings, N.D.; Morton, F.R.; Kok, C.Y.; Kong, J.; Barrett, A.J. MEROPS: The peptidase database. Nucleic Acids Res. 2008, 36, D320–D325. [Google Scholar] [CrossRef] [PubMed]
- Blin, K.; Shaw, S.; Kloosterman, A.M.; Charlop-Powers, Z.; Van Wezel, G.P.; Medema, M.H.; Weber, T. antiSMASH 6.0: Improving cluster detection and comparison capabilities. Nucleic Acids Res. 2021, 49, W29–W35. [Google Scholar] [CrossRef] [PubMed]
- Lee, I.; Kim, Y.O.; Park, S.C.; Chun, J. OrthoANI: An improved algorithm and software for calculating average nucleotide identity. Int. J. Syst. Evol. Microbiol. 2016, 66, 1100–1103. [Google Scholar] [CrossRef] [PubMed]
- Chun, J.; Oren, A.; Ventosa, A.; Christensen, H.; Arahal, D.R.; da Costa, M.S.; Rooney, A.P.; Yi, H.; Xu, X.W.; De Meyer, S.; et al. Proposed minimal standards for the use of genome data for the taxonomy of prokaryotes. Int. J. Syst. Evol. Microbiol. 2018, 68, 461–466. [Google Scholar] [CrossRef] [PubMed]
- Goris, J.; Konstantinidis, K.T.; Klappenbach, J.A.; Coenye, T.; Vandamme, P.; Tiedje, J.M. DNA-DNA hybridization values and their relationship to whole-genome sequence similarities. Int. J. Syst. Evol. Microbiol. 2007, 57, 81–91. [Google Scholar] [CrossRef] [PubMed]
- Chakraborty, S.; Khopade, A.; Biao, R.; Jian, W.; Liu, X.Y.; Mahadik, K.; Chopade, B.; Zhang, L.; Kokare, C. Characterization and stability studies on surfactant, detergent and oxidant stable α-amylase from marine haloalkaliphilic Saccharopolyspora sp. A9. J. Mol. Catal. B Enzym. 2011, 68, 52–58. [Google Scholar] [CrossRef]
- Gangwar, M.; Dogra, S.; Gupta, U.P.; Kharwar, R.N. Diversity and biopotential of endophytic actinomycetes from three medicinal plants in India. Afr. J. Microbiol. Res. 2014, 8, 184–191. [Google Scholar] [CrossRef]
- Sreevidya, M.; Gopalakrishnan, S.; Kudapa, H.; Varshney, R.K. Exploring plant growth-promotion actinomycetes from vermicompost and rhizosphere soil for yield enhancement in chickpea. Brazilian J. Microbiol. 2016, 47, 85–95. [Google Scholar] [CrossRef]
- Anwar, S.; Ali, B.; Sajid, I. Screening of rhizospheric actinomycetes for various in-vitro and in-vivo plant growth promoting (PGP) traits and for agroactive compounds. Front. Microbiol. 2016, 7, 1334. [Google Scholar] [CrossRef]
- Kumsiri, B.; Pekkoh, J.; Pathom-aree, W.; Lumyong, S.; Phinyo, K.; Pumas, C.; Srinuanpan, S. Enhanced production of microalgal biomass and lipid as an environmentally friendly biodiesel feedstock through actinomycete co-culture in biogas digestate effluent. Bioresour. Technol. 2021, 337, 125446. [Google Scholar] [CrossRef] [PubMed]
- Lian, J.; Wijffels, R.H.; Smidt, H.; Sipkema, D. The effect of the algal microbiome on industrial production of microalgae. Microb. Biotechnol. 2018, 11, 806–818. [Google Scholar] [CrossRef] [PubMed]
- Chorazyczewski, A.M.; Huang, I.S.; Abdulla, H.; Mayali, X.; Zimba, P.V. The Influence of Bacteria on the Growth, Lipid Production, and Extracellular Metabolite Accumulation by Phaeodactylum tricornutum (Bacillariophyceae). J. Phycol. 2021, 57, 931–940. [Google Scholar] [CrossRef] [PubMed]
- Vuong, T.T.; Kwon, B.R.; Eom, J.I.; Shin, B.K.; Kim, S.M. Interaction between marine bacterium Stappia sp. K01 and diatom Phaeodactylum tricornutum through extracellular fatty acids. J. Appl. Phycol. 2020, 32, 71–82. [Google Scholar] [CrossRef]
- Seymour, J.R.; Amin, S.A.; Raina, J.-B.; Stocker, R. Zooming in on the phycosphere: The ecological interface for phytoplankton–bacteria relationships. Nat. Microbiol. 2017, 2, 17065. [Google Scholar] [CrossRef] [PubMed]
- Meza, B.; de-Bashan, L.E.; Hernandez, J.P.; Bashan, Y. Accumulation of intra-cellular polyphosphate in Chlorella vulgaris cells is related to indole-3-acetic acid produced by Azospirillum brasilense. Res. Microbiol. 2015, 166, 399–407. [Google Scholar] [CrossRef] [PubMed]
- Meza, B.; de-Bashan, L.E.; Bashan, Y. Involvement of indole-3-acetic acid produced by Azospirillum brasilense in accumulating intracellular ammonium in Chlorella vulgaris. Res. Microbiol. 2015, 166, 72–83. [Google Scholar] [CrossRef]
- Kamei, K.; Yamamura, Y.; Hara, S.; Ikenaka, T. Amino acid sequence of chitinase from Streptomyces erythraeus. J. Biochem. 1989, 105, 979–985. [Google Scholar] [CrossRef]
- Mayer, C.; Vocadlo, D.J.; Mah, M.; Rupitz, K.; Stoll, D.; Warren, R.A.J.; Withers, S.G. Characterization of a beta-N-acetylhexosaminidase and a beta-N-acetylglucosaminidase/beta-glucosidase from Cellulomonas fimi. FEBS J. 2006, 273, 2929–2941. [Google Scholar] [CrossRef]
- Kitamura, M.; Okuyama, M.; Tanzawa, F.; Mori, H.; Kitago, Y.; Watanabe, N.; Kimura, A.; Tanaka, I.; Yao, M. Structural and functional analysis of a glycoside hydrolase family 97 enzyme from Bacteroides thetaiotaomicron. J. Biol. Chem. 2008, 283, 36328–36337. [Google Scholar] [CrossRef]
- Côté, A.; Shareck, F. Cloning, purification and characterization of two lipases from Streptomyces coelicolor A3(2). Enzyme Microb. Technol. 2008, 42, 381–388. [Google Scholar] [CrossRef]
- Lesuisse, E.; Schanck, K.; Colson, C. Purification and preliminary characterization of the extracellular lipase of Bacillus subtilis 168, an extremely basic pH-tolerant enzyme. Eur. J. Biochem. 1993, 216, 155–160. [Google Scholar] [CrossRef] [PubMed]
- Yang, J.; Huang, X.; Tian, B.; Wang, M.; Niu, Q.; Zhang, K. Isolation and characterization of a serine protease from the nematophagous fungus, Lecanicillium psalliotae, displaying nematicidal activity. Biotechnol. Lett. 2005, 27, 1123–1128. [Google Scholar] [CrossRef] [PubMed]
- Gerber, N.N.; Lechevalier, H.A. Geosmin, an Earthy-Smelling Substance Isolated from Actinomycetes. Appl. Microbiol. 1965, 13, 935–938. [Google Scholar] [CrossRef]
- Zaroubi, L.; Ozugergin, I.; Mastronardi, K.; Imfeld, A.; Law, C.; Gélinas, Y.; Piekny, A.; Findlay, B.L. The Ubiquitous Soil Terpene Geosmin Acts as a Warning Chemical. Appl. Environ. Microbiol. 2022, 88. [Google Scholar] [CrossRef] [PubMed]
- Czech, L.; Hermann, L.; Stöveken, N.; Richter, A.A.; Höppner, A.; Smits, S.H.J.; Heider, J.; Bremer, E. Role of the extremolytes ectoine and hydroxyectoine as stress protectants and nutrients: Genetics, phylogenomics, biochemistry, and structural analysis. Genes 2018, 9, 177. [Google Scholar] [CrossRef] [PubMed]
- Weber, T.; Laiple, K.J.; Pross, E.K.; Textor, A.; Grond, S.; Welzel, K.; Pelzer, S.; Vente, A.; Wohlleben, W. Molecular analysis of the kirromycin biosynthetic gene cluster revealed beta-alanine as precursor of the pyridone moiety. Chem. Biol. 2008, 15, 175–188. [Google Scholar] [CrossRef]
- Vogeley, L.; Palm, G.J.; Mesters, J.R.; Hilgenfeld, R. Conformational change of elongation factor Tu (EF-Tu) induced by antibiotic binding. Crystal structure of the complex between EF-Tu.GDP and aurodox. J. Biol. Chem. 2001, 276, 17149–17155. [Google Scholar] [CrossRef]
- McClure, R.A.; Goering, A.W.; Ju, K.S.; Baccile, J.A.; Schroeder, F.C.; Metcalf, W.W.; Thomson, R.J.; Kelleher, N.L. Elucidating the Rimosamide-Detoxin Natural Product Families and Their Biosynthesis Using Metabolite/Gene Cluster Correlations. ACS Chem. Biol. 2016, 11, 3452–3460. [Google Scholar] [CrossRef]
- Crone, W.J.K.; Leeper, F.J.; Truman, A.W. Identification and characterisation of the gene cluster for the anti-MRSA antibiotic bottromycin: Expanding the biosynthetic diversity of ribosomal peptides. Chem. Sci. 2012, 3, 3516–3521. [Google Scholar] [CrossRef]
- Franz, L.; Kazmaier, U.; Truman, A.W.; Koehnke, J. Bottromycins—Biosynthesis, synthesis and activity. Nat. Prod. Rep. 2021, 38, 1659–1683. [Google Scholar] [CrossRef] [PubMed]
- Todorova, A.K.; Jüttner, F.; Linden, A.; Plüiss, T.; von Philipsborn, W. Nostocyclamide: A New Macrocyclic, Thiazole-Containing Allelochemical from Nostoc sp. 31 (Cyanobacteria). J. Org. Chem. 1995, 60, 7891–7895. [Google Scholar] [CrossRef]
- Jüttner, F.; Todorova, A.K.; Walch, N.; Von Philipsborn, W. Nostocyclamide M: A cyanobacterial cyclic peptide with allelopathic activity from Nostoc 31. Phytochemistry 2001, 57, 613–619. [Google Scholar] [CrossRef] [PubMed]
- Martins, J.; Vasconcelos, V. Cyanobactins from Cyanobacteria: Current Genetic and Chemical State of Knowledge. Mar. Drugs 2015, 13, 6910–6946. [Google Scholar] [CrossRef] [PubMed]
- Kudo, F.; Motegi, A.; Mizoue, K.; Eguchi, T. Cloning and characterization of the biosynthetic gene cluster of 16-membered macrolide antibiotic FD-891: Involvement of a dual functional cytochrome P450 monooxygenase catalyzing epoxidation and hydroxylation. Chembiochem 2010, 11, 1574–1582. [Google Scholar] [CrossRef] [PubMed]
- Luo, Y.; Huang, H.; Liang, J.; Wang, M.; Lu, L.; Shao, Z.; Cobb, R.E.; Zhao, H. Activation and Characterization of a Cryptic Polycyclic Tetramate Macrolactam Biosynthetic Gene Cluster. Nat. Commun. 2013, 4, 2894. [Google Scholar] [CrossRef] [PubMed]
- Purev, E.; Kondo, T.; Takemoto, D.; Niones, J.T.; Ojika, M. Identification of ε-Poly-L-lysine as an Antimicrobial Product from an Epichloë Endophyte and Isolation of Fungal ε-PL Synthetase Gene. Molecules 2020, 25, 1032. [Google Scholar] [CrossRef]
- Wang, L.; Zhang, C.; Zhang, J.; Rao, Z.; Xu, X.; Mao, Z.; Chen, X. Epsilon-poly-L-lysine: Recent Advances in Biomanufacturing and Applications. Front. Bioeng. Biotechnol. 2021, 9, 895. [Google Scholar] [CrossRef]
- Cortina, N.S.; Revermann, O.; Krug, D.; Müller, R. Identification and Characterization of the Althiomycin Biosynthetic Gene Cluster in Myxococcus xanthus DK897. ChemBioChem 2011, 12, 1411–1416. [Google Scholar] [CrossRef]
- Gerc, A.J.; Song, L.; Challis, G.L.; Stanley-Wall, N.R.; Coulthurst, S.J. The Insect Pathogen Serratia marcescens Db10 Uses a Hybrid Non-Ribosomal Peptide Synthetase-Polyketide Synthase to Produce the Antibiotic Althiomycin. PLoS ONE 2012, 7, e44673. [Google Scholar] [CrossRef]
- Yushchuk, O.; Ostash, I.; Mösker, E.; Vlasiuk, I.; Deneka, M.; Rückert, C.; Busche, T.; Fedorenko, V.; Kalinowski, J.; Süssmuth, R.D.; et al. Eliciting the silent lucensomycin biosynthetic pathway in Streptomyces cyanogenus S136 via manipulation of the global regulatory gene adpA. Sci. Rep. 2021, 11. [Google Scholar] [CrossRef] [PubMed]
- Kim, J.D.; Kang, J.E.; Kim, B.S. Postharvest disease control efficacy of the polyene macrolide lucensomycin produced by Streptomyces plumbeus strain CA5 against gray mold on grapes. Postharvest Biol. Technol. 2020, 162, 111115. [Google Scholar] [CrossRef]
- Völler, G.H.; Krawczyk, J.M.; Pesic, A.; Krawczyk, B.; Nachtigall, J.; Süssmuth, R.D. Characterization of new class III lantibiotics--erythreapeptin, avermipeptin and griseopeptin from Saccharopolyspora erythraea, Streptomyces avermitilis and Streptomyces griseus demonstrates stepwise N-terminal leader processing. Chembiochem 2012, 13, 1174–1183. [Google Scholar] [CrossRef] [PubMed]
- Vikeli, E.; Widdick, D.A.; Batey, S.F.D.; Heine, D.; Holmes, N.A.; Bibb, M.J.; Martins, D.J.; Pierce, N.E.; Hutchings, M.I.; Wilkinson, B. In situ activation and heterologous production of a cryptic lantibiotic from an african plant ant-derived saccharopolyspora species. Appl. Environ. Microbiol. 2020, 86. [Google Scholar] [CrossRef] [PubMed]
- Won, C.; Shen, X.; Mashiguchi, K.; Zheng, Z.; Dai, X.; Cheng, Y.; Kasahara, H.; Kamiya, Y.; Chory, J.; Zhao, Y. Conversion of tryptophan to indole-3-acetic acid by tryptophan aminotransferases of Arabidopsis and YUCCAs in Arabidopsis. Proc. Natl. Acad. Sci. USA 2011, 108, 18518–18523. [Google Scholar] [CrossRef]
- Croft, M.T.; Lawrence, A.D.; Raux-Deery, E.; Warren, M.J.; Smith, A.G. Algae acquire vitamin B12 through a symbiotic relationship with bacteria. Nature 2005, 438, 90–93. [Google Scholar] [CrossRef]
- Park, J.; Park, B.S.; Wang, P.; Patidar, S.K.; Kim, J.H.; Kim, S.-H.; Han, M.-S. Phycospheric Native Bacteria Pelagibaca bermudensis and Stappia sp. Ameliorate Biomass Productivity of Tetraselmis striata (KCTC1432BP) in Co-cultivation System through Mutualistic Interaction. Front. Plant Sci. 2017, 8, 289. [Google Scholar] [CrossRef]
- Kazamia, E.; Czesnick, H.; Van Nguyen, T.T.; Croft, M.T.; Sherwood, E.; Sasso, S.; Hodson, S.J.; Warren, M.J.; Smith, A.G. Mutualistic interactions between vitamin B12-dependent algae and heterotrophic bacteria exhibit regulation. Environ. Microbiol. 2012, 14, 1466–1476. [Google Scholar] [CrossRef]

| BGC Number | Cluster Type | Most Similar Known Cluster | Similarity |
|---|---|---|---|
| 1 | NRPS, transAT-PKS, T1PKS, bottromycin, cyanobactin | Kirromycin biosynthetic gene cluster from Streptomyces collinus Tu 365 | 57% |
| 2 | T1PKS | FD-891 biosynthetic gene cluster from Streptomyces graminofaciens | 50% |
| 3 | NRPS, T1PKS | SGR PTMs biosynthetic gene cluster from Streptomyces griseus subsp. griseus NBRC 13350 | 66% |
| 4 | NAPAA | ε-Poly-L-lysine biosynthetic gene cluster from Epichloe festucae | 100% |
| 5 | Terpene | Geosmin biosynthetic gene cluster from Streptomyces coelicolor A3(2) | 100% |
| 6 | Terpene | Isorenieratene biosynthetic gene cluster from Streptomyces griseus subsp. griseus NBRC 13350 | 57% |
| 7 | NRPS-like, NRPS, T1PKS | Althiomycin biosynthetic gene cluster from Myxococcus xanthus | 100% |
| 8 | T1PKS | Lucensomycin biosynthetic gene cluster from Streptomyces cyanogenus | 68% |
| 9 | Ectoine | Ectoine biosynthetic gene cluster from Streptomyces anulatus | 100% |
| 10 | RRE-containing, lanthipeptide-class-III | Ery-9 biosynthetic gene cluster from Saccharopolyspora erythraea NRRL 2338 | 100% |
| 11 | Lanthipeptide-class-II | Kyamicin biosynthetic gene cluster from Saccharopolyspora sp. | 100% |
| Type | Locus Tag | Mibig Cluster | Mibig Protein ID | ID % | Coverage % | Cluster, Host |
|---|---|---|---|---|---|---|
| NRPS | OOZ19_02780 | BGC0001760 | WP_004571777.1 (RmoI) | 57.0 | 107.8 | Rimosamide, Streptomyces rimosus subsp. rimosus ATCC 10970 |
| NRPS | OOZ19_02890 | BGC0001070 | CAN89633.1 (KirAIII) | 61.0 | 102.0 | Kirromycin, Streptomyces collinus Tu 365 |
| T1PKS | OOZ19_02875 | CAN89636.1 (KirAVI) | 56.0 | 101.4 | ||
| NRPS | OOZ19_02865 | CAN89638.1 (KirB) | 64.0 | 99.0 | ||
| RIPP-like | OOZ19_02920 | BGC0001157 | CBG72695.1 | 70 | 100.5 | Bottromycin A2, Streptomyces scabiei 87.22 |
| OOZ19_02925 | CBG72688.1 | 67 | 96.4 | |||
| OOZ19_02930 | CBG72689.1 | 62 | 102.6 | |||
| OOZ19_02935 | CBG72690.1 | 65.0 | 92.8 | |||
| OOZ19_02940 | CBG72691.1 | 70.0 | 100.2 | |||
| OOZ19_02945 | CBG72692.1 | 65.0 | 92.1 | |||
| OOZ19_02950 | CBG72693.1 | 56.0 | 98.7 | |||
| OOZ19_02955 | CBG72694.1 | 85.0 | 89.1 | |||
| OOZ19_02960 | CBG72695.1 | 72.0 | 99.1 | |||
| OOZ19_02965 | CBG72696.1 | 63.0 | 99.6 | |||
| RIPP-like | OOZ19_02990 | BGC0001632 | KXS89937.1 | 40.0 | 105.9 | Kawaguchipeptin A, Microcystis aeruginosa NIES-88 |
| RIPP-like | OOZ19_03000 | BGC0002629 | RFP52076.1 | 41.0 | 100.6 | Limnothamide biosynthetic gene cluster, Limnothrix sp. CACIAM 69d |
| Type | Locus Tag | Mibig Cluster | Mibig Protein ID | ID % | Coverage % | Cluster, Host |
|---|---|---|---|---|---|---|
| T1PKS | OOZ19_03940 | BGC0000058 | BAJ16467.1 (GFSA) | 46.0 | 102.4 | FD-891, Streptomyces graminofaciens |
| NRPS, T1PKS | OOZ19_04725 | BGC0001046 | BAG17643.1 (SGR_814) | 64.0 | 102.4 | SGR PTM, Streptomyces griseus |
| OOZ19_04730 | BAG17642.1 (SGR_813) | 63.0 | 96.7 | |||
| OOZ19_04735 | BAG17641.1 (SGR_812) | 77.0 | 98.2 | |||
| OOZ19_04740 | BAG17640.1 (SGR_811) | 66.0 | 100.0 | |||
| NAPAA | OOZ19_07305 | BGC0002174 | BBU42014.1 (EPLS) | 48.0 | 97.4 | ε-Poly-L-lysine, Epichloe festucae |
| NRPS, T1PKS | OOZ19_10385 | BGC0000955 | CCA29202.1 (AlmA) | 49.0 | 101.9 | Althiomycin, Myxococcus xanthus |
| OOZ19_10380 | CCA29203.1 (AlmB) | 51.0 | 102.5 | |||
| OOZ19_10375 | CCA29204.1 (AlmF) | 53.0 | 97.3 | |||
| T1PKS | OOZ19_12435 | BGC0002333 | QSE03591.1 (LcmC) | 62.0 | 100.7 | Lucensomycin, Streptomyces cyanogenus |
| OOZ19_12440 | QSE03601.1 (LcmB) | 49.0 | 100.5 | |||
| OOZ19_12445 | QSE03603.1 (LcmE) | 55.0 | 103.8 | |||
| RRE-containing, lanthipeptide-class-III | OOZ19_26865 | BGC0000513 | CAM03499.1 | 72.0 | 99.2 | Ery-9, Saccharopolyspora erythraea NRRL 2338 |
| OOZ19_26870 | CAM03500.1 | 67.0 | 102.1 | |||
| OOZ19_26875 | CAM03501.1 | 100.0 | 100.0 | |||
| OOZ19_26880 | CAM03502.1 | 69.0 | 99.6 | |||
| Lanthipeptide-class-III | OOZ19_28805 | BGC0002346 | QDF63352.1 (KyaR1) | 68.0 | 94.8 | Kyamicin, Saccharopolyspora sp. |
| OOZ19_28810 | QDF63353.1 (Kyaorf11) | 77.0 | 91.5 | |||
| OOZ19_28815 | QDF63354.1 (KyaL) | 73.0 | 99.6 | |||
| OOZ19_28820 | QDF63355.1 (KyaK) | 71.0 | 99.7 | |||
| OOZ19_28825 | QDF63356.1 (KyaR) | 84.0 | 99.5 | |||
| OOZ19_28830 | QDF63357.1 (KyaN) | 72.0 | 100.0 | |||
| OOZ19_28835 | QDF63358.1 (KyaA) | 78.0 | 100 | |||
| OOZ19_28840 | QDF63359.1 (KyaM) | 74.0 | 99.7 | |||
| OOZ19_28845 | QDF63360.1 (KyaX) | 78.0 | 100.3 | |||
| OOZ19_28850 | QDF63361.1 (KyaT) | 90.0 | 99.7 | |||
| OOZ19_28855 | QDF63362.1 (KyaH) | 82.0 | 100.0 |
Disclaimer/Publisher’s Note: The statements, opinions and data contained in all publications are solely those of the individual author(s) and contributor(s) and not of MDPI and/or the editor(s). MDPI and/or the editor(s) disclaim responsibility for any injury to people or property resulting from any ideas, methods, instructions or products referred to in the content. |
© 2023 by the authors. Licensee MDPI, Basel, Switzerland. This article is an open access article distributed under the terms and conditions of the Creative Commons Attribution (CC BY) license (https://creativecommons.org/licenses/by/4.0/).
Share and Cite
Bertrand, C.D.F.; Martins, R.; Quintas-Nunes, F.; Reynolds-Brandão, P.; Crespo, M.T.B.; Nascimento, F.X. Saccharopolyspora sp. NFXS83 in Marine Biotechnological Applications: From Microalgae Growth Promotion to the Production of Secondary Metabolites. Microorganisms 2023, 11, 902. https://doi.org/10.3390/microorganisms11040902
Bertrand CDF, Martins R, Quintas-Nunes F, Reynolds-Brandão P, Crespo MTB, Nascimento FX. Saccharopolyspora sp. NFXS83 in Marine Biotechnological Applications: From Microalgae Growth Promotion to the Production of Secondary Metabolites. Microorganisms. 2023; 11(4):902. https://doi.org/10.3390/microorganisms11040902
Chicago/Turabian StyleBertrand, Constança D. F., Rodrigo Martins, Francisco Quintas-Nunes, Pedro Reynolds-Brandão, Maria T. B. Crespo, and Francisco X. Nascimento. 2023. "Saccharopolyspora sp. NFXS83 in Marine Biotechnological Applications: From Microalgae Growth Promotion to the Production of Secondary Metabolites" Microorganisms 11, no. 4: 902. https://doi.org/10.3390/microorganisms11040902
APA StyleBertrand, C. D. F., Martins, R., Quintas-Nunes, F., Reynolds-Brandão, P., Crespo, M. T. B., & Nascimento, F. X. (2023). Saccharopolyspora sp. NFXS83 in Marine Biotechnological Applications: From Microalgae Growth Promotion to the Production of Secondary Metabolites. Microorganisms, 11(4), 902. https://doi.org/10.3390/microorganisms11040902

